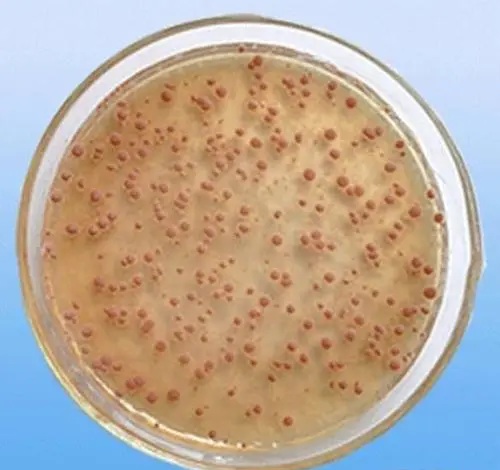

硝化系統異常的原因及解決方法
污水處理中硝化反應異常問題綜述:硝化系統的混合溶液。

硝化系統
當酸堿度降低時,硝化效率降低。混合溶液的pH值正常,但硝化效率下降。活性污泥沉降速度太慢;二沉水中出現渾濁、針狀絮體四種現象的原因及解決方法是什么?
硝化系統異常現象一:硝化系統混合液pH值降低,硝化效率降低,出水NH3-N濃度升高。
原因及解決方法如下:
堿度不足。檢查二沉池出水的堿度。如果小于20毫克/升,可以判斷是堿度不足引起的,因此應進行堿度核算,確定堿用量。
酸性廢水從進水中排出。檢查進水污水的酸堿度。如果太低,可以表示酸性廢水排放。可采取石灰中和處理等臨時措施,同時加強上游污染源管理。
硝化系統異常現象二:混合液pH值正常,但硝化效率下降,出水NH3-N濃度升高。
原因及解決方法如下:
氧氣供應不足。檢查混合溶液的溶解氧值是否小于2毫克/升,如果溶解氧過低,增加曝氣量。
溫度太低了。檢查進水污水或混合液溫度是否明顯降低,影響硝化效果。解決方案可以包括增加曝氣池的數量或增加混合溶液的濃度。傳入TKN負載過高。檢查流入污水中的TKN濃度是否增加。如果上升,應增加投入運行的曝氣池數量或增加曝氣池的MLVSS數,同時增加曝氣量。
硝化細菌數量不足。首先檢查是否有過多的排泥,如果排泥量過大,減少排泥量;其次,檢查二沉池內是否因某種原因有泥漿上浮,導致污泥流失,并采取控制措施。如果不是以上兩個原因,檢查進水污水的BOD5/TKN是否過大,降低了MLVSS硝化細菌的比例。可以增加初沉池的停留時間,降低生化需氧量/TKN值。
硝化細菌
硝化系統異常現象三:活性污泥沉降速度太慢。
原因及解決方法如下:
污泥中毒。檢查活性污泥的耗氧率SOUR和硝化率NR是否下降。若減量過多,則確認污泥中毒,應查找污水中毒物來源,加強上游污染源管理。
硝化系統異常現象四:二沉出水渾濁,攜帶針狀絮體。
原因及解決方法如下:
二沉出水的渾濁是由于活性污泥中硝化細菌比例過高造成的,可以適當提高BOD5/TKN值,但不應影響硝化效果。
由于生物硝化是一個低負荷或超低負荷的過程,活性污泥沉降速度過快,一些游離的細小絮體無法被有效捕獲,因此出水攜帶針狀絮體是不可避免的。控制針絮凝的有效措施是增加污泥排放量,降低SRT,但這必然會影響硝化效果,使出水NH3-N超標。在實際操作中,首先要權衡是解決針絮問題重要還是保持高效硝化重要,然后再采取操作控制措施。
推薦閱讀:《如何降低工業污水中的氨氮?(教你兩招輕松降氨氮)》

